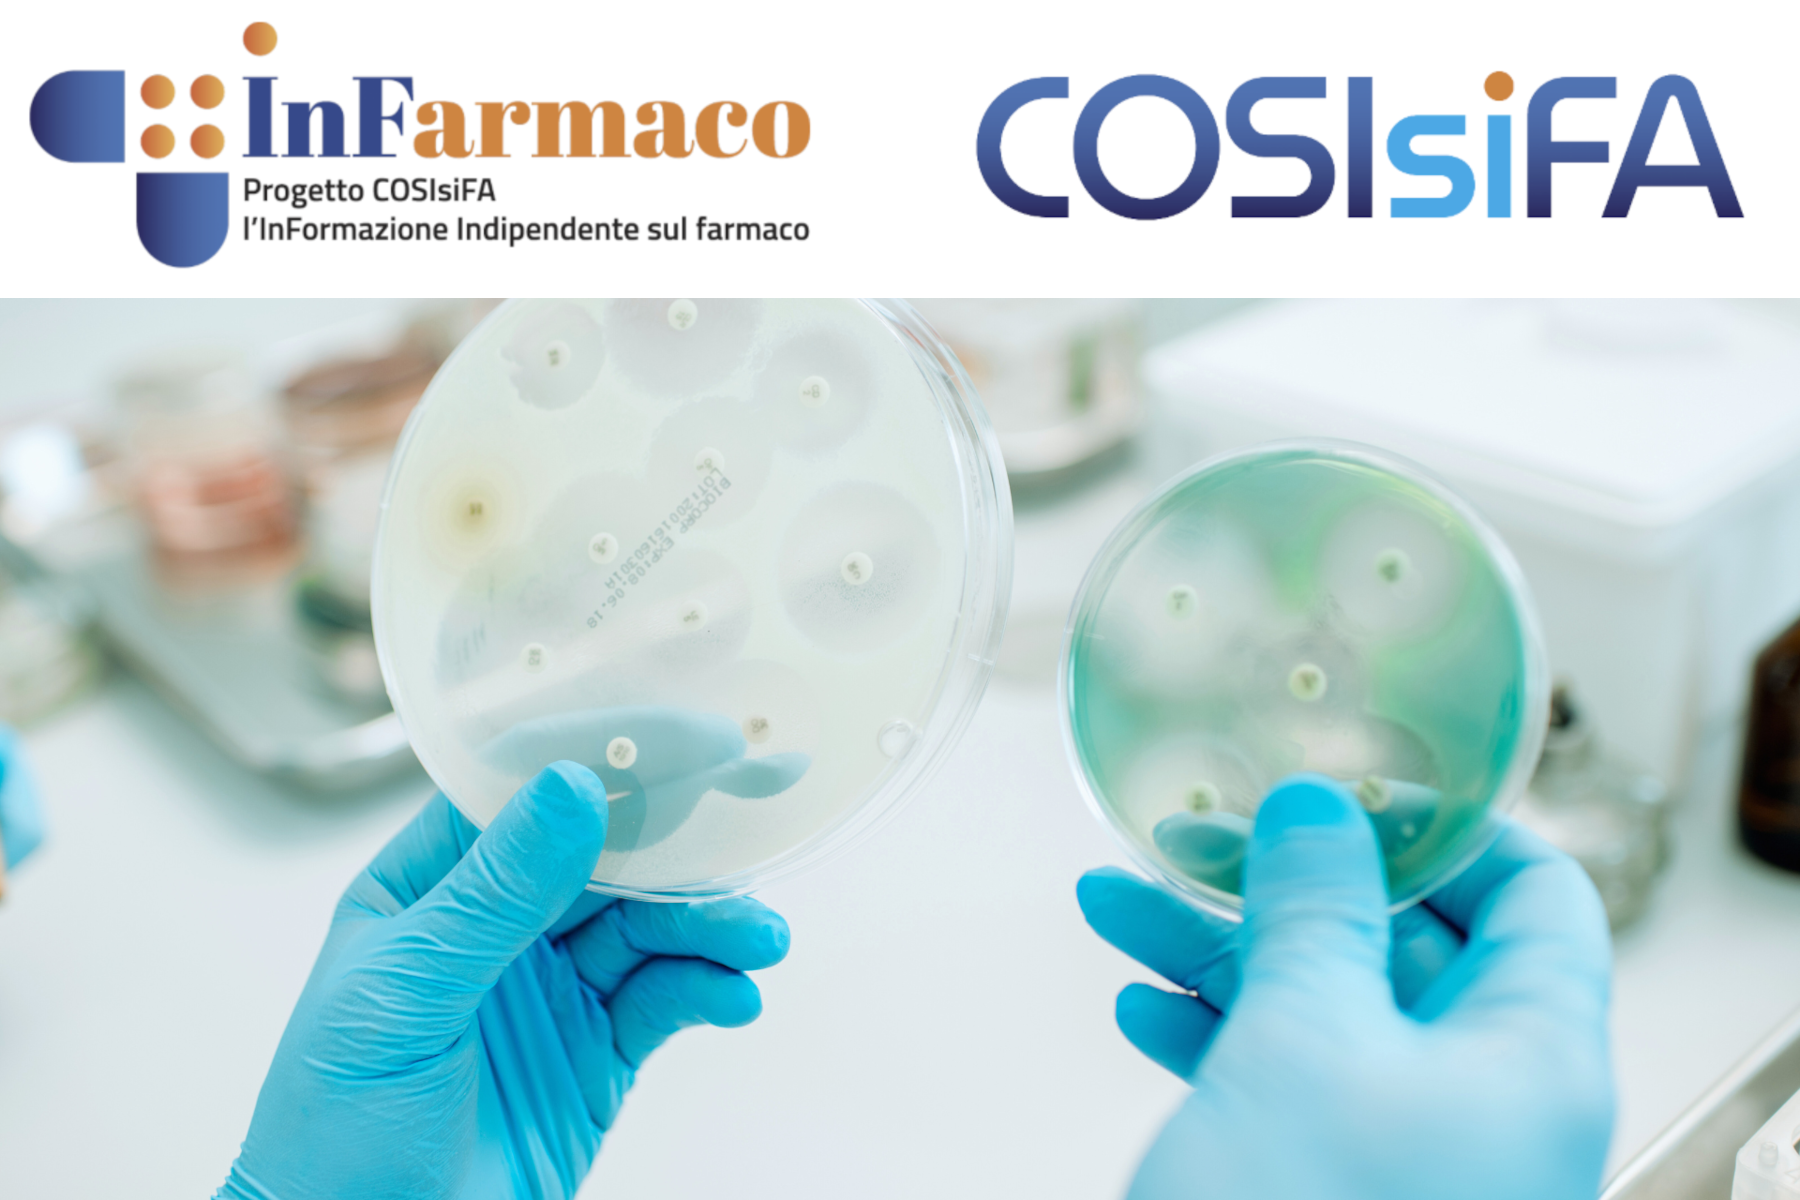

La piattaforma indipendente
per la tua formazione continua
Uso appropriato degli antibiotici (con approfondimenti EBM)
Corso FAD ECM per tecnici audiometristi
Perché seguire questo corso FAD ECM sull'uso appropriato degli antibiotici?
L’antibiotico resistenza rappresenta oggi una delle maggiori minacce per la salute pubblica a livello globale. I dati epidemiologici mostrano che il nostro Paese è tra quelli con il più alto consumo di antibiotici in Europa e con una prevalenza significativa di batteri resistenti. L’uso inappropriato di questi farmaci – sia in termini di scelta del principio attivo sia di durata della terapia – favorisce l’emergere di resistenze, riduce l’efficacia dei trattamenti, aumenta i costi sanitari e può comportare eventi avversi per i pazienti.
In questo contesto, promuovere l’uso corretto degli antibiotici è una priorità imprescindibile. Non si tratta soltanto di “prescrivere meno”, ma di prescrivere meglio, integrando i principi dell’evidence based medicine (EBM) con i criteri di appropriatezza condivisi a livello internazionale.
Questo corso FAD ECM, parte del progetto COSIsiFA, è stato pensato per fornire ai professionisti sanitari strumenti pratici e aggiornati per migliorare la gestione delle infezioni e contribuire alla riduzione delle resistenze batteriche, rendendo le decisioni cliniche più sicure e consapevoli.
Che cosa imparerai seguendo questo corso
Al termine del percorso, il partecipante avrà acquisito competenze nell’analisi critica della letteratura scientifica e nella valutazione della validità e trasferibilità degli studi clinici, incluse revisioni sistematiche e metanalisi. Saprà applicare i principi di appropriatezza prescrittiva nella pratica clinica quotidiana, conoscerà strumenti digitali come app dedicate all'uso appropriato degli antibiotici così da contribuire a diffondere questi contenuti nel proprio contesto professionale.
A chi è dedicato questo corso ECM
Il corso è aperto a tutti gli operatori sanitari delle Regioni aderenti all'iniziativa.
Che cosa comprende il corso
La formazione si articola in quattro moduli con propedeuticità progressiva, ciascuno caratterizzato da momenti sincroni (webinar su piattaforma Zoom) e materiali fruibili in modalità asincrona sulla piattaforma SAEPE. Sono previsti questionari di valutazione per ogni modulo, con soglia di superamento al 75%, e un questionario di gradimento finale con possibilità di lasciare commenti in aperto sul corso svolto. I partecipanti avranno inoltre accesso a uno slide kit da utilizzare per attività formative locali, favorendo la disseminazione dei messaggi chiave sull’appropriatezza prescrittiva degli antibiotici.